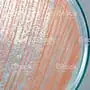
enter image description here

I have noticed that my water will leave a slimy pink film on certain surfaces like a sink drain, bath toys, or dog water bowl. What would cause this and how can I fix it?
3 Answers
What you're most likely looking at is a bacteria called Serratia Marcescens.
According to Wikipedia it is:
commonly found growing in bathrooms (especially on tile grout, shower corners, toilet water line, and basin)
as well as many other places.
From that source (and others), the best way to get rid of it is regular cleaning by soaking & scrubbing with bleach-based disinfectants.
- 7,241
- 3
- 28
- 42
It is an airborne bacterium that grows in moist environments. This kind of bacteria is harmless and you can wipe it off easily. You can also disinfect areas affected by it by using vinegar and water. There is no way get rid of it totally since you can never get rid of bacteria in the air. You can prevent it to reappear often by keeping moist/damp areas in your home dry and clean. Ventilation is key. For things that are wet most of the time like bath toys, dog bowls, etc. Take the time to clean them every once in a while and dry it out completely.
- 131
- 1
I've also been doing research for a school project (relating to reddish and bluish stains on water fixtures) and some sources had said that the red stains are from copper. In other words i'm assuming copper has entered your water through the pipes and the only way to fix the issue would be to essentially replace the pipes in general. Bluish stains resort from iron as well.